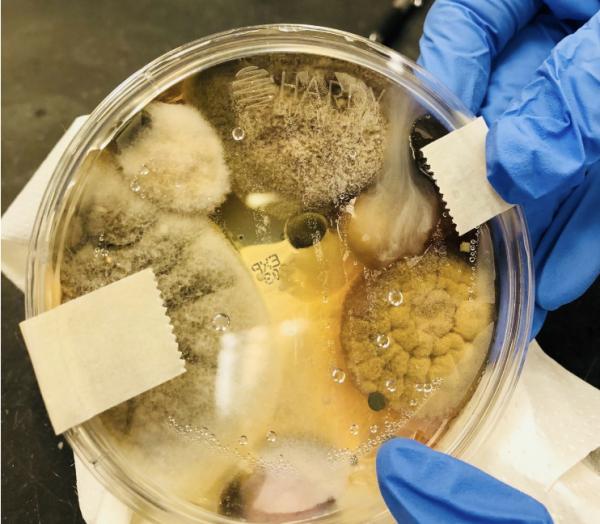

There is a bar/restaurant in my town called ####### and I rarely eat there. As in not in the last 40 years. Yet, people I know do and many tell me that the food is quite good. So last year when I was invited to dinner I figured I'd give it a try.
Before eating I needed to wash my hands, so it was off to the restroom, on which hangs a vaguely disturbing sign that reads:
"We know our bathroom sucks. Deal with it."
Joke, right?
No.
They weren't kidding. The tiny bathroom looked like the place had hosted a bulimics retreat during a C. diff outbreak. It made subway toilets look like those pristine rooms where microchips are manufactured. The toilet. OMG. It would seem that the patrons thought that the term "Flushing" was nothing more than a neighborhood in Queens. I washed (but did not dry) my hands and got the hell out of there as if Satan himself was chasing me.
I survived the meal. In fact, it was rather good, but I can't unsee that bathroom and have since avoided the restaurant like the plague (which was probably one of the pathogens growing in the bathroom). Perhaps I survived because I wrapped a sweater tightly around my head (picture: Afghan women) to avoid inhaling whatever godforsaken microbes that were competing in a mad dash to enter my nasal passages. (Better idea for next time: use a plastic bag and duct tape around the neck like they do in mafia movies.
Not that I would have stayed long enough to use it, but there was one saving grace. There wasn't one of those hideous Petri dishes called electric hand dryers, although I would have dried my hands on barbed wire if forced to choose. I hate those damn things. And I'm not alone.
A new study from the University of Connecticut and Quinnipiac University shows that hot-air dryers may be acting like bacterial bombs, shooting loads of spores from bathroom air directly onto your hands.
Lovely. And taking it a bit further...
Whenever you use a hand dryer in a public restroom just remember “It’d be more hygienic to let disease-ridden gibbons sneeze your hands dry"
Dr. Sheldon Cooperon Twitter. (Damn, what a great line. Wish I thought of it.)
And speaking of Petri dishes, the following was a bit disconcerting...
A viral Facebook post from 2018 showed what happened when a woman named Nicole Ward left a Petri dish inside an electric hand dryer for three minutes and then incubated it for two days. This happened. (Keep in mind that no one knows whether this experiment was done right or whether whatever grew on the plate was harmful or not. And note that she was selling a soap product ($10 off!) in the same post. Still...

Yuck. Photo: Facebook
It would seem that not all dryers are equal. Dyson makes The Dyson Airblade™ which, according to the company "capture[s] 99.97% of particles, as small as 0.3 microns, including bacteria and viruses." That sounds pretty good, but does it really matter? Maybe not.
Unfortunately, every time a lidless toilet is flushed, it aerosolizes a fine mist of microbes. This fecal cloud may disperse over an area as large as six square meters (65 square feet).
Jon Ross, M.D., Harvard Medical School "The bacterial horror of hot-air hand dryers"
Approximately zero percent of public toilets have a lid and perhaps 0.01% of people (none of them men) at home bother to put the lid down after sending Mr. Dougie to his watery grave. Some joker from Reddit offered the following, which is, at best, marginally helpful:
I get around this by storing my toothbrush in my ass.
Hmm. Wonder if there's any room up there. My cutlery takes up a lot of space.
So, are we doomed in both public and private bathrooms? Probably not. Harvard's Dr. Ross estimates the risk of both:
"Remember that your chances of picking up a serious pathogen in a restroom are small. Direct contact with other people is much more likely as a means of acquiring infection."
Jon Ross, M.D., Harvard Medical School
Which brings up a different issue.
A new study by Puronics revealed that while Americans claim they’re washing their hands, nearly one-third of Americans admit to not washing their hands after using the restroom.
Hey slobs. Are you one of them? Come clean!
Finally
Should you be on the fence about whether to use one of the damn things or not, we at ACSH are fortunate to have our own "investigator," who was already onto this issue this decades ago...
Hand Dryers are a menace. My phobia of hand dryers began the second a roach went flying out of one in a dirty restaurant bathroom (is there any other kind) in the 80s.
Julie Kasel, ACSH Research Associate

Photo credits: Bill Walsh, Flickr, Freesrvg.com